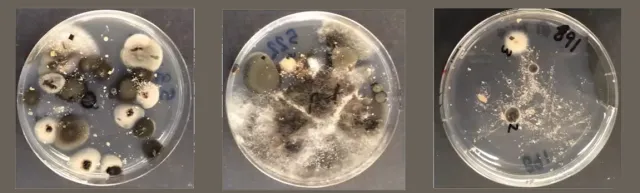
endophytes

2022 Invasive Species Action Week Lunchtime Talks

Some are tiny and hard to find. Some are beautiful. However, as with many things, looks can be deceiving. Invasive plants and animals threaten some of California's most precious resources, as well as our health. Often these impacts involve surprising interactions that may not be obvious.
The 2022 Invasive Species Action Week Lunchtime Talks explored some of these invasives and what can be done to stop their spread. See the individual descriptions of the talks below to view the recordings.
Monday, June 6

Successful Biological Control of Asian Citrus Psyllid in California
Presented by Dr. Ivan Milosavljevic
Asian citrus psyllid (ACP) is an invasive pest of citrus that was first detected in California in 2008. ACP poses a significant threat to the long-term viability of the California citrus industry because of its ability to vector a bacterium that causes a lethal citrus disease, called huanglongbing. The disease was first detected in urban-grown citrus in 2012.
In California, ACP has been the target of a biological control program with parasitoids from the pest's native range. In California-grown citrus, ACP benefits from Argentine ants that protect it from natural enemies, and in return, immature ACP (nymphs) provide ants with honeydew, a feeding waste product that is a source of nutritive sugars. Since the inception of the biological control program targeting ACP in California, pest densities have declined by approximately 70%. Control of Argentine ants significantly increases the efficacy of natural enemies against ACP.
This successful biological control program substantially reduces ACP densities in urban areas, which may significantly slow the spread of huanglongbing disease in Southern California into commercial citrus production areas and will be the focus of our discussion.
![]() | Dr. Ivan Milosavljevic is a Supervisory Project Scientist in biological control at the University of California, Riverside. He works on the biological control of invasive pest species that attack agricultural crops, threaten wilderness areas, and degrade urban landscapes in California. As a Research Affiliate for the Center for Invasive Species Research, he is regularly engaged in emerging programs concerning invasive pests such as Asian citrus psyllid and Argentine ants (citrus pests), a variety of sap sucking citrus pests (aphids, scale, mealybugs, psyllids), palm weevils (exotic palm pests), and avocado seed weevils (exotic avocado pests), and wireworms (soil pests). |
Tuesday, June 7

Planting Right with PlantRight
Presented by Alex Simmons (Stubblefield)
Many invasive plants are attractive, which is not surprising given that many were originally brought to California as ornamentals. Hear about ways the horticultural trade is working to stop the spread of invasive plants now and in the future through the PlantRight partnership, and learn what you can do to make sure your landscaping does not contribute to the problem.
![]() | Alex Simmons (Stubblefield) has been the PlantRight program manager since October 2019 when she oversaw the transition of the program from Sustainable Conservation to Plant California Alliance. In 2021, she successfully relaunched the PlantRight retail nursery survey, and shortly after was promoted to Associate Director of Plant California Alliance. Alex currently serves on all Plant California Alliance committees including PlantRight, CCN Pro, Research, and Scholarships. She holds a Bachelor’s degree in Sustainable Agriculture and Food Systems from UC Davis and Associate’s degrees in Biological and Natural Sciences from Sierra College. |
Wednesday, June 8

Biodiversity, Conservation, and Why We Need Killer Dragonflies
to Keep People and Our Ecosystems Healthy
Presented by Dr. Gary Bucciarelli
In this talk, Dr. Gary Bucciarelli discusses how stream biodiversity in California is impacted by invasive crayfish, how this ultimately affects human health, and what we can do to preserve our incredible (and dwindling!) freshwater ecosystems.
Invasive red swamp crayfish are a serious problem in the Santa Monica Mountains and other parts of Southern California. They devastate native wildlife, including threatened species such as the California red-legged frog, throwing off the natural balance of ecosystems.
They also pose a threat to people, because they lead to more mosquitos and risk of disease. In the mountains, mosquito populations are kept in check by dragonfly nymphs, which voraciously consume their aquatic larvae. But invasive crayfish disrupt that predator-prey relationship, killing and driving dragonfly nymphs from waterways.
![]() | Dr. Gary Bucciarelli is the Director of Research at the UC Natural Reserve System's Stunt Ranch Biological Field Station that is located in the heart of the Santa Monica Mountains in Los Angeles. He works in freshwater ecosystems to understand how invasive species, drought, warming temperatures, and habitat loss are affecting amphibians and stream biodiversity. |
Thursday, June 9
Emerging Insights on Invasive Shothole Borers in California
Presented by Dr. Shannon Lynch
Invasive shothole borers have become established in many parts of Southern California, and emerging research suggests that other parts of the state are at risk including the Central Valley, Sacramento, the Bay Area and the Coachella Valley (Palm Springs). This presentation includes promising research on using endophytes (bacterial and fungal microbes that live in trees) to control the tree-killing Fusarium fungus that the beetles "farm" in their galleries to use as their primary food source. Additional research to be discussed includes the model used to predict future spread of the beetles and their potential economic impact.
![]() | Currently a post-doc at UC Davis’ Department of Plant Pathology, Dr. Shannon Lynch works extensively in Southern California studying the invasive shothole borers and developing a statewide strategic initiative to control and manage this emergent pest-disease complex. Shannon received her undergraduate degree from UC Berkeley in 2001, majoring in Integrative Biology. She received her Ph.D. in 2020 from UC Santa Cruz, where she studied Environmental Studies with a designated emphasis in Ecology and Evolutionary Biology. She will be joining SUNY College of Environmental Science and Forestry as Assistant Professor in Forest Pathology and Forest Health in the fall of this year. |
Friday, June 10

Early Detection & Rapid Response in the Sacramento-San Joaquin Delta
Presented by Dr. Rachel Wigginton
The Sacramento-San Joaquin Delta is a highly invaded system, and long-term management of existing invasive species populations is challenging for regional natural resource managers. The Delta Interagency Invasive Species Coordination (DIISC) Team has been leading efforts to plan how to prevent, detect, and quickly respond to novel invasions in the Delta. Early Detection and Rapid Response (EDRR) are a coordinated set of actions that aim to find and report, then eradicate potential invasive species before they spread and cause harm. In the Delta, EDRR efforts have been siloed by taxonomic group or organizational jurisdiction. Additionally, there are few structures to coordinate actions among groups with existing EDRR programs, and few communication structures between broader prevention and monitoring efforts and EDRR programs. To respond to this need, the DIISC team developed a draft EDRR framework for the region and coordinated a Symposium on the topic of EDRR. Beyond these EDRR efforts, the DIISC Team seeks to advance research on preventing and managing invasion in restored sites.
![]() | Dr. Rachel Wigginton is a Senior Environmental Scientist at the Sacramento-San Joaquin Delta Conservancy. As part of the Delta Conservancy’s mission to lead efforts that protect, enhance, and restore the Delta’s environment, Dr. Wigginton facilitates the Delta Interagency Invasive Species Coordination (DIISC) Team. The DIISC Team seeks to foster communication and collaboration among California state agencies, federal agencies, research and conservation groups, and other stakeholders that detect, prevent, and manage invasive species and restore invaded habitats in the Sacramento-San Joaquin Delta. Before coming to the Delta Conservancy, Rachel completed her PhD in Ecology at UC Davis studying the impacts of invasive plants in tidal wetlands. |




